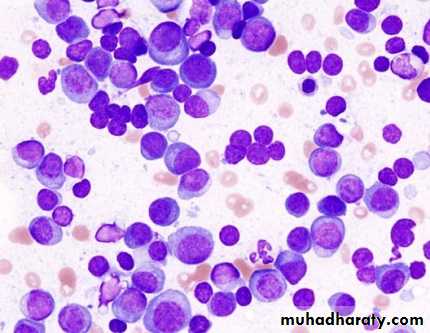
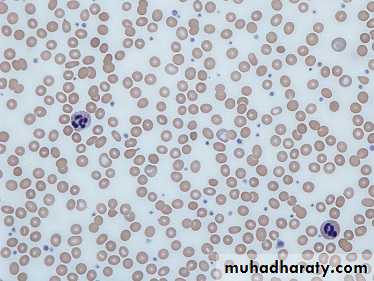

m
Multiple Myeloma
Malignant proliferation of plasma cells.• Normal plasma cell form Ig which contain heavy and light chain
• Normal variety of Ig polyclonal & each contain Kappa &
• Lambda light chain
• Myeloma plasma cell : Ig of single heavy and light chain
• lead to monoclonal protein (para protein)
• In some light chain may be only produced and appear in
• urine as Bence-Jones proteinuria.
• Incidence : 4 new cases/100,000 peoples/year.
• Sex ratio : M:F → 2:1
• Age : median age 60-70 years.
• Etiology : Unknown,chemical, enviromental
Classification of MM
• Paraprotein frequency %• IgG 55%
• IgA 21%
• Light chain only 22%
• Other (D, E, non secretory) 2%
• The diagnosis of MM requires two of the following
marrow plasmacytosis.
Serum and/or urinary paraprotein
+
≥ 1 of `` CRAB``
MM: Clinical Manifestations
Series of genetic mutations, translocations, normal cell turns malignantHallmarks of myeloma: CRAB (also known as myeloma defining events;MDE)A = Anemia
B = Bone Disease
C = Hypercalcemia
R = RenalComplications
* Not an MDE, yet relatively common
Recurrent infections*
Rajkumar SV, et al. Lancet Oncol. 2014;15:e538-e548.
Multiple Myeloma
• Symptoms• Effect
• Pathology
• Pain
• Severe local pain
• Lethergy,
• thirst
• Anaemia& tiredness
• Bone erosion due to stimulation of oesteoclast.
• Pathological fracture
• Hypercalcaemia
• BM failure
• Marrow involvement with malignant plasma cell
• Renal damage
• Increased blood viscosity
• Amylidosis -renal damage
• Excess production of light chains and paraprotein
• Infection (Resp.)
• Impaired immune function
• Reduction in number of normal plasma cells
Clinical features
• Weight loss ,malaise and fatigue.
• Bone pain found in 60% of cases at the back and ribs.
• Anorexia , diarrhea, vomiting, constipation, polyuria, polydipsia occur with hypercalcemia in 30%,
• Renal impairment due to hypercalcaemia and dehydration present in 50% .
• Pneumococcal, chest and urinary tract infection due to low immunoglobulin(Ig) production.
• Headache , Confusion, Breathlessness, Visual Disturbance and bleeding can occur secondary to hyperviscosity (IgA).
• 5% present with paralysis secondary to spinal cord compression by extra-dural plasma cell mass.
• Carpal-tunnel syndrome, nephrotic syndrome, cardiac failure and neuropathy secondary to amyloid deposition.
• Absence of immunoparaesis should cast doubt on diagnosis.
• Only about 5% of pts with ESR persistently above 100 mm in the 1st hour have meyeloma.Republished with permission of American Society of Hematology, from Ghobrial, IM, et al. How I treat smoldering multiple myeloma, Blood. 2014;124:3380-3388; permission conveyed through Copyright Clearance Center, Inc.
Revised IMWG Criteria (2014)
Initial Approach to Treatment of Myeloma
Nontransplant Candidate
(based on age, performance status, and comorbidities)Induction treatment
Transplant
Candidate
Induction treatment
(4-6 cycles)
Stem cell harvest
Stem cell transplantation
Maintenance
Maintenance
Consolidation therapy?
19501960
19701980
1990
20002010
Increased Treatment Options in MMMM Therapies Introduction
1962
Prednisone
1986
High-dose dexamethasone
FDA Approved in MM
2006
Lenalidomide + dex2nd line; Thalidomide + dex 1st line
2007
Doxorubicin + bortezomib2nd line
2003
Bortezomib 3rd line
2005
Bortezomib 2nd line
1958
Melphalan
1969
Melphalan +
prednisone
1983
Autologous
transplantation
2015
2008
Bortezomib frontline2013
Pomalidomide 3rd line
2012
Carfilzomib
3rd line; Bortezomib SC
2014
Bortezomib retreatment
2015
Panobinostat 3rd line; Lenalidomide 1st line
Supportive Care
Bone: 85% will develop bone disease
All should receive monthly bisphosphonates after dental exam; monitor renal function long term
Infection: major cause of death in MM
Impaired antibody formation after antigenic stimulations
Immunizations: pneumococcal (PCV13, PPSV23), seasonal inactivated influenza
Shingles prophylaxis (proteasome inhibitor, transplant)
Renal: monitor status, dose reductions may be necessary
Acute renal failure can occur due to NSAIDs, CT dyes, antibiotics
Hydrate (carefully), monitor monthly
Bilotti E, et al. Clin J Oncol Nurs. 2011;15(suppl):5-8. Miceli TS, et al. Clin J Oncol Nurs. 2011;15(suppl):9-23. Faiman B, et al. Clin J Oncol Nurs. 2011;15 66-76. MMWR. 2014;46:1-24.
Management- Cont…
• Allopurinol to prevent urate nephropathy.• Plasmapheresis, if necessary, for hyperviscosity
**Chemotherapy with or without HSCT
In older patients, thalidomide combined with the alkylating agent melphalan and prednisolone has increased the median overall survival to more than 4 years.• In younger, fitter patients, standard treatment includes first-in chemotherapy to maximum response and then an autologous HSCT
Cont.-Management
1-BORTEZOMIB(VELCADE) VTD+Z2- Thalidomide
3-Lenalidomide(Revlimid) VRD+Z
4- Dexamethasone
5-Bisphosphonate (Zoledronate)
Treatment is administered until paraprotein levels have stopped falling. This is termed‘plateau phase’ and can last for weeks or years.
Radiotherapy; for localised bone pain and for pathological fractures.
It is also useful for the emergency treatment of spinal cord compression complicating extradural plasmacytomas
Long-term Effects of Treatment
Diarrhea (lenalidomide)Peripheral neuropathy (bortezomib, MM, diabetes)
Secondary cancers
Cardiovascular/pulmonary disease
Health maintenance is important as patients are at risk for same illnesses as those without MM
Financial
Chronic illnesses are costly
Loss of income, hospital and medical bills can be high
• Refer to patient care organizations, copay foundations
Faiman B. J Adv Pract Oncol. 2013;4:354-360. Kurtin S, et al. Clin J Oncol Nurs. 2013;17(suppl):7-11. Faiman B, et al. Blood. 2013;122:5397.
Waldenstrӧm macroglobulinaemia
This is a low-grade lymphoplasmacytoid lymphoma associated with an IgM paraprotein.Patients classically present with features of hyperviscosity,such as nosebleeds, bruising, confusion and visual disturbance.
Anaemia, systemic symptoms, splenomegaly or lymphadenopathy
Investigation; have an IgM paraprotein associated with a raised plasma viscosity. The bone marrow with infiltration of lymphoid cells and prominent mast cells.
TREATMENT
1-Plasmapheresis for anaemia and hyperviscosity.2- Chlorambucil
3- Fludarabine
4- Rituximab
*Monoclonal gammopathy of uncertain significance (MGUS);
a paraprotein is present in the blood but with no other features of myeloma, Waldenstrӧm macroglobulinaemia, lymphoma or related disease.The bone marrow may have increased plasma cells but these usually constitute less than 10% of nucleated cells.
After follow-up of 20 years, only one-quarter of cases will progress to myeloma
or a related disorder (i.e.around 1% per annum)